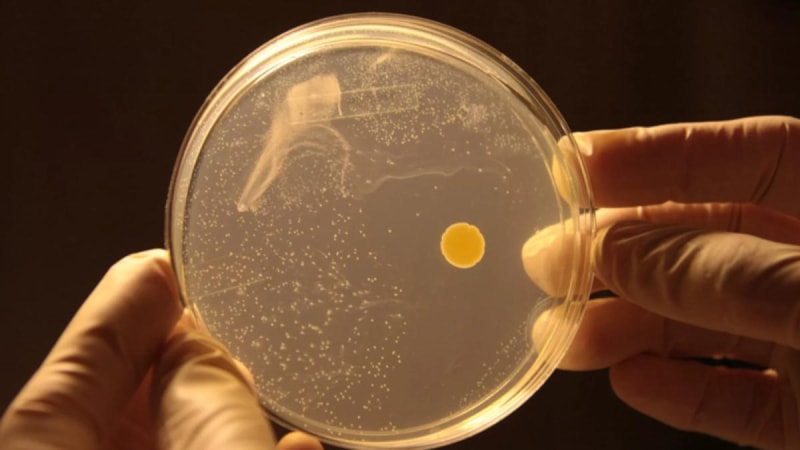

Ünlü fizikçi Nikola Tesla, havadaki nemden elektrik elde etmek istiyordu. Günümüzde ise Tesla'nın bu fikri gerçeğe dönüşebilir.
Ünlü fizikçi Nikola Tesla, fırtına bulutlarında meydana gelen süreçlerden yararlanarak havadaki nemden elektrik elde etmek istiyordu.
Tesla'nın ölümünden 80 yıl sonra, bilim insanları bu fikri hayata geçirebilmek için çeşitli çalışmalar yürütüyor. Peki gelecekte gerçekten de havadan elektrik elde edebilir miyiz?
Havadan elektrik enerjisi çalışmaları
Havada elektrik üretmek, dünyanın enerji ihtiyacını karşılamak için yeni bir yol olabilir. Hava, sürekli olarak hareket halinde olan ve potansiyel enerji taşıyan bir ortamdır. Bu enerjiyi elektrik enerjisine dönüştürmek için farklı yöntemler üzerinde çalışmalar yürütülüyor.
Massachusetts Amherst Üniversitesi'nden Jun Yao ve ekibi, yalnızca nemli havadan elektrik elde edebilecek bir teknoloji geliştiriyor.
Nikola Tesla ve diğerleri bunu geçmişte araştırdı, ancak hiçbir zaman umut verici sonuçlara ulaşamadı. Ancak bu durum yakında değişebilir.

Dünya çapında çok sayıda araştırma grubu, havada doğal olarak yüzen su moleküllerinden elektrik elde etmenin yeni yollarını keşfediyor.
Bu mümkün, çünkü bu su molekülleri kendi aralarında küçük elektrik yüklerini aktarabiliyorlar.
Buradaki zorluk, kullanılabilir olmaya yetecek kadar elektriği toplamaktır. Ancak bilim insanları artık minyatür bilgisayarlara veya sensörlere güç sağlamaya yetecek kadar elektrik elde edebilecekleri inanıyor.
Bu durum, neredeyse 7/24 etrafımızda gezinebilecek yeni bir yenilenebilir enerji biçiminin umut verici ihtimalini artırıyor.
İlk çalışmalar 2020'de başladı
2020'de Yao ve meslektaşları, bir bakteri tarafından üretilen küçük protein nanotellerinin havadan nasıl elektrik toplayabildiğini açıklayan bilimsel bir makale yayınladı.
Kesin mekanizma hala tartışılıyor, ancak malzemenin küçük gözeneklerinin yüzen su moleküllerini yakalayabildiği görüldü. Malzemeye sürtündükçe, su molekülleri de ona yük veriyor gibi görünüyor.
Yao, böyle bir sistemde çoğu molekülün yüzeye yakın kaldığını ve çok miktarda elektrik yükü biriktirdiğini, diğer birkaç molekülün ise daha derinlere nüfuz ettiğini söylüyor. Bu, malzeme katmanının üst ve alt kısımları arasında yük farkı yaratıyor.
Bu, su moleküllerinin hareketini etkileyerek ve yük ayrımı için doğru koşulları yaratarak elektrik üretebileceğiniz anlamına gelir. Yao, "Cihaz kelimenin tam anlamıyla dünyanın her yerinde çalışabilir." diyor.

2020'de yayınlanan bu makale, buz dağının sadece görünen kısmıydı. Yao ve meslektaşları, Mayıs 2023'te, nano gözeneklerle dolu, ancak grafen oksit pullarından ve polimerlerden türetilen selüloz nano liflerine kadar çeşitli farklı malzemeler kullanarak, aynı tür yapıyı oluşturdukları bir çalışma yayınladılar.
Küçük farklılıklarla da olsa hepsi işe yaradı. Bu, malzemenin kendisinden ziyade yapının önemli olduğunu gösteriyor.
Az da olsa elektrik üretildi
Şu ana kadar yapılan deneylerde, insan saçından daha ince olan cihazlar, bir voltun çok küçük bir kısmına eşdeğer, çok küçük miktarlarda elektrik üretti.
Yao, daha fazla malzeme yaparak veya parçalarını birbirine bağlayarak birden fazla volt ve daha yüksek faydalı yükler elde etmeye başlayabileceğinizi öne sürüyor.
Araştırmaya dahil olmayan, İngiltere'deki Imperial College London'da malzeme mühendisi olan Reshma Rao, "Bunun gerçekten heyecan verici olduğunu düşünüyorum." diyor.
Yine de Rao, böyle bir teknolojinin tüm binalara veya arabalar gibi enerji tüketen makinelere güç sağlayacağını hayal etmenin gerçekçi olmayabileceği konusunda uyarıyor.
Ancak havadaki nem, yalnızca sensörler veya küçük giyilebilir elektronik cihazlar gibi nesnelerin internetine bağlı cihazlara güç sağlamak için yeterli olabilir.

Bununla birlikte, Jun Yao nemli havayı potansiyel bir enerji kaynağı olarak araştıran tek ekip değil. 2020 yılında İsrail'de bir grup, nemli havayı iki metal parçası arasından geçirerek elektrik elde etmeyi başardı. Nemli hava metalin üzerinden akarken üzerinde bir yük oluşmasına neden oldu.
Bu fenomen, ilk kez 1840 yılında İngiltere'nin kuzeydoğusundaki Newcastle'ın kuzeyinde, bir kömür madeninde çalışan tren sürücüsünün motoru çalıştırırken elinde garip bir karıncalanma hissi hissettiğinde fark edildi.
Daha sonra sürücü, parmağıyla aracın kollarından birinin arasında küçük bir kıvılcımın sıçradığını fark etti. Olayı araştıran bilim insanları, buharın motor kazanının metaline sürtünmesinin yük birikmesine neden olduğu sonucuna vardı .
İsrail'deki Tel Aviv Üniversitesi'nde atmosfer bilimleri alanında araştırmacı olan ve 2020 tarihli makalenin ortak yazarı Colin Price, küçük metal parçaları kullanılarak yapılan laboratuvar deneylerinde üretilen yüklerin çok düşük olduğunu söylüyor.
Ancak kendisinin ve meslektaşlarının sistemlerini iyileştirmek için çalıştıklarını da ekliyor.

Bir çalışma da Portekiz'den
Bu arada Portekiz'deki başka bir ekip, aynı zamanda nemli havayı enerji kaynağı olarak kullanmayı amaçlayan, Avrupa Birliği tarafından finanse edilen CATCHER adlı bir proje üzerinde çalışıyor.
Portekiz'in Lizbon kentindeki Lusófona Üniversitesi'nde malzeme bilimcisi olan Svitlana Lyubchyk, projeyi koordine ediyor.
Lyubchyk, "Mühendislik prototipinin aşağı yukarı bu yılın sonuna kadar hazır olacağını düşünüyorum." diyor.
Lyubchyk, zirkonyum oksitten yapılmış yaklaşık 4 cm çapında gri bir disk gösteriyor ve bu malzemenin nemli havadaki su moleküllerini yakalayıp onları küçük kanallardan akmaya zorlayabildiğini söylüyor.
Bunun, tek bir diskten yaklaşık 1,5 volt sağlamaya yetecek bir elektrik yükü ürettiği belirtiliyor.
LED'e güç sağlamak için yalnızca iki diskin yeterli olduğunu iddia eden Lyubchyk, daha da büyük bir çıktı oluşturmak için malzemenin çok daha fazla parçasının birbirine zincirlenebileceğini de sözlerine ekledi.
Ancak çalışmayla ilgili bazı bilgiler çevrimiçi olarak mevcut olsa da ekibin en son deneyleriyle ilgili tüm ayrıntılar henüz yayınlanmadı veya hakemler tarafından incelenmedi.
Grup, ayrıca disklerin LED'e güç sağlamak için nasıl bağlandığını gösteren herhangi bir materyali paylaşmayı da reddetti.
Bilim insanları, havadan elektrik elde etme çabaları hakkında araştırılacak daha çok şeyin olduğunun farkında.
Kanada'daki McGill Üniversitesi'nde enerji kararlarının çevresel ve ekonomik değiş tokuşları üzerinde çalışan inşaat mühendisi Sarah Jordaan, bunun gibi bir teknolojiyi ticarileştirmeye çalışan herkesin, diğer yenilenebilir kaynaklarla karşılaştırıldığında yeterli güç çıktısını ve maliyet rekabetçiliğini kanıtlaması gerektiğini söylüyor.
Rüzgar ve güneş gibi daha yerleşik yenilenebilir enerji teknolojileri açıkça bir adım önde. Fosil yakıtlardan uzaklaşmanın özellikle acil olduğu bir dönemde, önümüzdeki on yılda muhtemelen çok daha önemli olacaklar.



